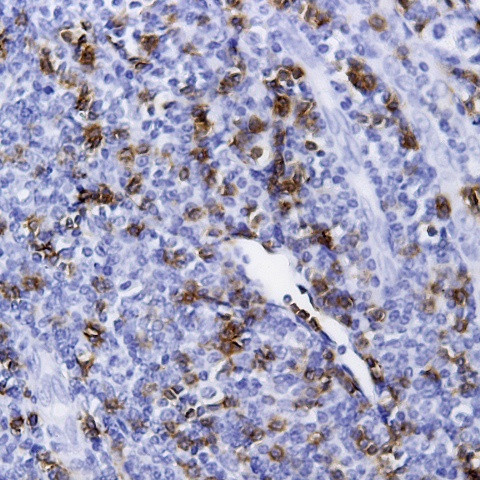
CD79a Antibody in Immunohistochemistry (Paraffin) (IHC (P))

Search
AbboMax
CD79a Polyclonal Antibody
{{$productOrderCtrl.translations['antibody.pdp.commerceCard.promotion.promotions']}}
{{$productOrderCtrl.translations['antibody.pdp.commerceCard.promotion.viewpromo']}}
{{$productOrderCtrl.translations['antibody.pdp.commerceCard.promotion.promocode']}}: {{promo.promoCode}} {{promo.promoTitle}} {{promo.promoDescription}}. {{$productOrderCtrl.translations['antibody.pdp.commerceCard.promotion.learnmore']}}
图: 1 / 1
CD79a Antibody (500-2494) in IHC (P)

产品信息
500-2494
种属反应
宿主/亚型
分类
类型
抗原
偶联物
形式
浓度
规格
纯化类型
保存液
内含物
保存条件
运输条件
产品详细信息
Positive control: Human tonsil tissue.
Cellular location: Cell membrane.
靶标信息
CD79a is a disulphide-linked heterodimer that includes B29 (CD79b) polypeptide. CD79a is a B lymphocyte antigen receptor with an antigen-specific surface component Ig (immunoglobulin) that associates with Ig-alpha and Ig-beta, necessary elements for the expression and function of the B-cell antigen receptor. CD79a first appears at pre-B cell stage and persists until the plasma cell stage where it is found as an intracellular component. CD79a is found in the majority of acute leukemias of precursor B cell type, in B cell lines, B cell lymphomas, and in some myelomas. It is not present in myeloid or T cell lines. Diseases associated with CD79a include Agammaglobulinemia 3 and Agammaglobulinemia, Non-Bruton type.
仅用于科研。不用于诊断过程。未经明确授权不得转售。
篇参考文献 (0)
生物信息学
蛋白别名: B-cell antigen receptor complex-associated protein alpha chain; B-cell antigen receptor complex-associated protein alpha chain-like; CD79; CD79a; CD79a antigen (immunoglobulin-associated alpha); CD79a molecule, immunoglobulin-associated alpha; extracellular domain; Ig alpha; Ig-alpha; immunoglobulin-associated alpha; MB-1 membrane glycoprotein; membrane-bound immunoglobulin associated protein; Membrane-bound immunoglobulin-associated protein; signal transduction via sig in B lymphocytes; putative; similar to Homo sapiens CD79A antigen (immunoglobulin-associated alpha) encoded by GenBank Accession Number U05259; Surface IgM-associated protein; unnamed protein product
基因别名: CD79A; Ig-alpha; IGA; IGAlpha; Ly-54; Ly54; MB-1; MB1
UniProt ID: (Human) P11912, (Mouse) P11911
Entrez Gene ID: (Human) 973, (Mouse) 12518, (Rat) 100913063